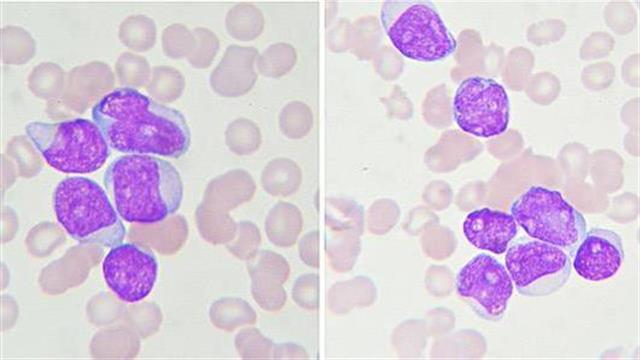
Εντοπίστηκε γενετική μετάλλαξη που συνδέεται με την παιδική λευχαιμία

Επιστήμονες εντόπισαν γενετική μετάλλαξη που συνδέεται με την οξεία λεμφοβλασιτκή λευχαιμία στα παιδιά.
Ο ερευνητής Dr. Kenneth Offit, του Memorial Sloan Kettering Cancer Center στη Νέα Υόρκη, δήλωσε ότι είναι το δεύτερο σύνδρομο ευαισθησίας στην λευχαιμία που περιγράφηκε πρόσφατα, υποδεικνύοντας ότι υπάρχει σημαντικό ποσοστό παιδικής λευχαιμίας που είναι κληρονομικό.
Η μετάλλαξη εντοπίζεται στο γονίδιο ETV6, που παίζει ρόλο στους καρκίνους των λεμφοκυττάρων. Η συγκεκριμένη γονιδιακή μετάλλαξη παρατηρήθηκε σε παιδιά με λευχαιμία που είναι μέλη της ίδιας οικογένειας.
Ο Offit δήλωσε ότι η μετάλλαξη προκαλεί σημαντικές αλλαγές στη λειτουργία του γονιδίου και πρόσθεσε ότι η ανακάλυψη συνεχίζει να παρέχει στοιχεία για τα κληρονομικά αίτια της παιδικής λευχαιμίας. Μας επιτρέπει να εμποδίσουμε τέτοια είδη λευχαιμίας στις μελλοντικές γενεές.
Άλλες έρευνες θα εξετάσουν τη συχνότητα των κληρονομικών μεταλλάξεων του ETV6 και άλλων γενετικών και μη γενετικών παραγόντων που επηρεάζουν τον κίνδυνο λευχαιμίας.
Η ερευνητική ομάδα προηγουμένως ανακάλυψε σχέση μεταξύ της παιδικής λευχαιμίας και του γονιδίου PAX5.
Η έρευνα δημοσιεύτηκε στο περιοδικό ''PLoS Genetics.''
Πηγές:
''PLoS Genetics.''
Ειδήσεις υγείας σήμερα
Απ. Παπαλάκης: Ραγδαία αύξηση περιστατικών καρκίνου της ουροδόχου κύστης
Τροφές που ενισχύουν την υγεία του εντέρου
Ο Ελληνικός Ερυθρός Σταυρός διοργανώνει τριήμερη εθελοντική αιμοδοσία στην Κάσο
Ελπίδες για τη θεραπεία της οξείας μυελογενούς λευχαιμίας στα παιδιά
Ελπίδες για τη θεραπεία της οξείας μυελογενούς λευχαιμίας στα παιδιά Ο Χοσέ Καρέρας συγκέντρωσε 3,4 εκατομμύρια ευρώ για το Ίδρυμα λευχαιμίας
Ο Χοσέ Καρέρας συγκέντρωσε 3,4 εκατομμύρια ευρώ για το Ίδρυμα λευχαιμίας Μηχανισμός κυτταρικής προστασίας προστατεύει από την οξεία μυελογενή λευχαιμία
Μηχανισμός κυτταρικής προστασίας προστατεύει από την οξεία μυελογενή λευχαιμία siREN: Χρυσό μετάλλιο στη θεραπευτική πρόταση του ΑΠΘ για τη χρόνια λεμφοκυτταρική λευχαιμία
siREN: Χρυσό μετάλλιο στη θεραπευτική πρόταση του ΑΠΘ για τη χρόνια λεμφοκυτταρική λευχαιμία Ελπίδες για τα παιδιά με λευχαιμία: Μέχρι και 90% πιθανότητες ίασης
Ελπίδες για τα παιδιά με λευχαιμία: Μέχρι και 90% πιθανότητες ίασης Λευχαιμία στα παιδιά - Καλύτερη θεραπεία με την τεχνητή νοημοσύνη
Λευχαιμία στα παιδιά - Καλύτερη θεραπεία με την τεχνητή νοημοσύνη Απ. Παπαλάκης: Ραγδαία αύξηση περιστατικών καρκίνου της ουροδόχου κύστης
Απ. Παπαλάκης: Ραγδαία αύξηση περιστατικών καρκίνου της ουροδόχου κύστης Τροφές που ενισχύουν την υγεία του εντέρου
Τροφές που ενισχύουν την υγεία του εντέρου Η πρώτη στον κόσμο μεταμόσχευση πνεύμονα από HIV-θετικό σε HIV-θετικό
Η πρώτη στον κόσμο μεταμόσχευση πνεύμονα από HIV-θετικό σε HIV-θετικό![Άσκηση με βάρη μειώνει τον κίνδυνο καρδιακών παθήσεων στις γυναίκες [μελέτη]](/media/articles/photos/thumb/141017-140655107652strengthtraining1280.jpg) Άσκηση με βάρη μειώνει τον κίνδυνο καρδιακών παθήσεων στις γυναίκες [μελέτη]
Άσκηση με βάρη μειώνει τον κίνδυνο καρδιακών παθήσεων στις γυναίκες [μελέτη] Ρύζι, πατάτες και ζυμαρικά: Ποιο είναι χειρότερο για το σάκχαρο;
Ρύζι, πατάτες και ζυμαρικά: Ποιο είναι χειρότερο για το σάκχαρο; Με ποιες τροφές να συνδυάζω ρύζι, πατάτες και ζυμαρικά για να μην αυξάνεται απότομα το σάκχαρο
Με ποιες τροφές να συνδυάζω ρύζι, πατάτες και ζυμαρικά για να μην αυξάνεται απότομα το σάκχαρο Pharmathen: Βαθιά κρίση και μηδενισμός αποτίμησης από funds της Partners
Pharmathen: Βαθιά κρίση και μηδενισμός αποτίμησης από funds της Partners Καρπούζι: Ποια είναι τα οφέλη του στην υγεία
Καρπούζι: Ποια είναι τα οφέλη του στην υγεία Ισχυρή πρωτιά της ΔΗΚΙ στις εκλογές του Ιατρικού Συλλόγου Αθηνών - Ρεκόρ συμμετοχής
Ισχυρή πρωτιά της ΔΗΚΙ στις εκλογές του Ιατρικού Συλλόγου Αθηνών - Ρεκόρ συμμετοχής Ιατρικός Σύλλογος Θεσσαλονίκης: Σαρωτική επικράτηση της ΕΝΟ.ΣΥ. - Ν.Ι.Κ.Ι.
Ιατρικός Σύλλογος Θεσσαλονίκης: Σαρωτική επικράτηση της ΕΝΟ.ΣΥ. - Ν.Ι.Κ.Ι. Φαρμακοβιομηχανίες σκέφτονται να χτυπήσουν την πόρτα της Εθνικής Αρχής Διαφάνειας
Φαρμακοβιομηχανίες σκέφτονται να χτυπήσουν την πόρτα της Εθνικής Αρχής Διαφάνειας Οι απρόσμενες συνέπειες της ολοκληρωτικής παράλειψης της ζάχαρης από τη διατροφή [μελέτη]
Οι απρόσμενες συνέπειες της ολοκληρωτικής παράλειψης της ζάχαρης από τη διατροφή [μελέτη]